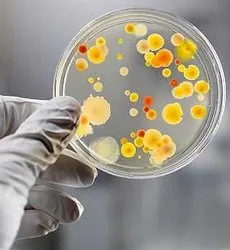
ორსულობა და ქლამიდიოზი

მომავალი დედა
 ორსულობის 29-ე კვირაზე ყველაზე მთავარი მომენტი თქვენი წონაა. ზედმეტი წონა არაფრად არგებს არც დედას და არც მომავალ ბავშვს. ზოგიერთი ქალი თვლის, რომ რახან ორსულადაა და ბავშვს ატარებს, საჭიროა ჩვეულებრივზე მეტი კვება, თუმცა ეს შეცდომაა.
ორსულობის 29-ე კვირაზე ყველაზე მთავარი მომენტი თქვენი წონაა. ზედმეტი წონა არაფრად არგებს არც დედას და არც მომავალ ბავშვს. ზოგიერთი ქალი თვლის, რომ რახან ორსულადაა და ბავშვს ატარებს, საჭიროა ჩვეულებრივზე მეტი კვება, თუმცა ეს შეცდომაა.
ბუნებამ თავად იცის რა ზომის და წონის უნდა იყოს ბავშვი და თავიდანვე უყალიბებს ისეთ ზომებს, რომელიც დედის მენჯის ზომებზე და შესაძლებლობებზეა მორგებული.
კვების მენიუში განსაკუთრებული კორექტივების შეტანა არ არის საჭირო. კვლავ არ არის რეკომენდებული - შემწვარი, ცხარე, შებოლილი და ზედმეტად მარილიანი პროდუქტები. ასევე - გამომცხვარი ტკბილი ნამცხვრები და სხვადასხვა ორცხობილა თუ ნამცხვარი. გარდა ამისა, თავი აარიდეთ ალერგენების შემცველ პროდუქტებს. უმჯობესია - ხაჭო, ხილი, ბოსტნეული, ფაფები, უცხიმო ხორცი და თევზი.
სითხის მიღების რეჟიმიც იგივეა, რაც წინა კვირებში, უბრალოდ საჭიროა მიღებული და გამოყოფილი სითხის რაოდენობის კონტროლი. თუ გამოყოფილი შარდის რაოდენობა ნაკლებია მიღებული სითხის რაოდენობაზე (მათ შორის სუფებისა და ხილის საშუალებით მიღებული სითხის), ეს ნიშნავს, რომ სითხე გროვდება ქსოვილებში და იწვევს შეშუპებებს.
ერთი სიტყვით, სითხის მიღებაში კორექტივების შეტანა საჭიროა მხოლოდ იმ შემთხვევაში, თუ ადგილი აქვს შეშუპებებს.
თუმცა, ზოგჯერ ეს შეშუპებები შეიძლება ვერც შეამჩნიოთ, რადგან იგი ვრცელდება არა მხოლოდ ხელებსა და ფეხებზე, არამედ შინაგან ორგანოებზე.
შეშუპებები მოწმობს, რომ თირკმლებს უჭირთ ზედმეტ დატვირთვასთან გამკლავება, ეს კი ჰესტოზის წინაპირობა შეძლება იყოს, რაც საფრთხის შემცველია მომავალი დედისა და ნაყოფის ჯანმრთელობისთვის.
კუჭის წვა, ღებინების შეგრძნება, ტკივილი ზურგის არეში (განსაკუთრებით ზურგზე წოლის დროს), უძილობა - ეს ის ფაქტორებია, რომელსაც შესაძლოა ადგილი ჰქონდეს 29-ე კვირაში (თუმცა ეს ინდივიდუალურია ყველა ორსულისთვის).
მთავარია, არ მოახდინით ამ პრობლემების პროვოცირება: მიირთვით საკვები მცირე პორციებით და კუჭის წვა არ იქნება აშკარად გამოხატული.
ნუ დაჯდებით უხერხულ პოზებში, არ ატაროთ მაღალქუსლიანი ფეხსაცმელი და წელის ტკივილი ნაკლებად შეგაწუხებთ.
შესაძლებლობის მიხედვით დასაძინებლად დაწექით ერთსა და იმავე დროს, კარგად განიავებულ ოთახში და უძილობაც შედარებით იოლად დაიძლევა.
ბავშვის მოძრაობა ამ პერიოდში უვე საკმაოდ საგრძნობია და ორსულობის განუყრელი ატრიბუტია. ეს ხდება იმიტომ, რომ პატარა სლოკინებს, შეუძლია შეხტეს შიშისგან, ეთამაშება საკუთარ ხელებს და ფეხებს და ა.შ.
ბავშვის თითეულ მოძრაობას დედა უკვე ნათლად გრძნობს. რა თქმა უნდა, უსიამოვნო შეგრძნებებს ეს არ იწვევს, თუმცა გარკვეული დისკომფორტი შეიძლება შეიქმნას კიდეც.
თუ აკონტროლებთ საკუთარ წონას, აკეთებთ მცირე სამკურნალო ხასიათის ვარჯიშებს და ცდილობთ მუდმივად იყოთ ფორმაში, ეს დადებითად აისახება თქვენს გარეგნობაზე, განწყობაზე, შესაბამისად კი ჯანმრთელობასა და ნაყოფის სრულყოფილად განვითარებაზე.
ბევრი მომავალი დედა ირწმუნება, რომ არასოდეს ისე სწრაფად არ ეზრდებოდა თმა, როგორც ორსულობის პერიოდში. ეს ნამდვილად ასეა, ჰორმონალური გარდაქმნები ხშირად დადებითად მოქმედებს თმის სტრუქტურაზე და მის საერთო მდგომარეობაზე.
სექსი ამ კვირაში დასაშვებია ისე, როგორც წინა კვირებში იმ შემთხვევების გარდა, როცა არსებობს რაიმე სახის უკუჩვენება და მომავალ დედას გაააჩნია ამის სურვილი. იხილეთ:
| ორსულობა და სექსი (კომპლექსური სახელმძღვანელო) |
უნდა აღინიშნოს, რომ ორსულობის დროს ბევრი დედა ნერვიულობს მოსალოდნელ მშობიარობაზე, იმ დონეზეც კი, რომ ზოგიერთი მათგანი მიდის დეპრესიამდე, რომელიც გრძელდება მშობიარობის შემდგომ პერიოდშიც.
იმისათვის, რომ ეს პროცესი არ გაღრმავდეს, ნუ უყურებთ მძაფრ და ნაღვლიან ფილმებსა და გადაცემებს, რომლებიც დაკავშირებულია ბავშვის დაბადებასთან, ან რაიმე სახის ფატალურ შემთხვევასთან. უმჯობესია ნახოთ და წაიკითხოთ მხოლოდ ბედნიერი ისტორიები პატარების ამ ქვეყნად მოვლინების შესახებ.
ადამიანს, ფსიქოლოგიურად შეუძლია განეწყოს იმგვარად, როგორც ეს მას სურს. ამიტომ, თქვენი ძირითადი ამოცანა უნდა იყოს ჯანმრთელი, მშვიდობიანი მშობიარობისთვის მზადყოფნის ფორმირება და მშობიარობის შემდგომი მოვლენების ადეკვატურად აღქმის უნარის ჩამოყალიბება.
დიახ, სწორედ ან პერიოდიდან არის საჭირო მშობიარობის შემდგომი დეპრესიის პროფილაქტიკა. დეპრესიის თავიდან ასაცილებლად და კარგი განწყობის ჩამოსაყალიბებლად, უმჯობესია წაიკითხოთ კარგი წიგნები, ან მოიძიოთ ინტერნეტში ხარისხიანი მასალა ახალშობილის ზრდა-განვითარების შესახებ.
მიღებული ინფორმაცია ძალიან გამოგადგებათ მომავალში, რამეთუ ბავშვის დაბადების პირველ თვეებში ნაკლებად გექნებათ კითხვისა და ინფორმაციის მიღების დრო და შესაძლებლობა.
მოსალოდნელი ნიშნები და შეგრძნებები
 • ხშირად - შეშუპებები;
• ხშირად - შეშუპებები;
• ტკივილი ზურგის არეში (სიმძიმის ცენტრის გადანაცვლების გამო);
• ზედმეტი დატვირთვა ფეხებზე (შესაძლოა თან ახლდეს ვენების ვარიკოზული გაგანიერება);
• წვივის კუნთების კრუნჩხვები (ორსულების 50%);
• გახშირებული შარდვა;
• გულის წასვლა (ჰემოგლობინის დაბალი დონის, დაბალი არტერიული წნევის, ქვედა ღრუ ვენას მიჭყლეტის გამო (არ არის რეკომენდებული ზურგზე წოლა);
• ზოგჯერ - ნაადრევი მშობიარობის დაწყება (საშვილოსნოს რითმული შეკუმშვა, რომელსაც თან ახლავს სისხლოვანი გამონადენი);
• გადაღლილობა ორსულობის გამო;
• ზოგჯერ - გულმავიწყობა
• ნაყოფის გადაბრუნება საშვილოსნოში, აქტიური ბიძგები ხელის მტევნებით;
გამოკვლევები
• სისხლის საერთო ანალიზი;
• შარდის საერთო ანალიზი;
• დოპლეროგრაფია (დოპლერომეტრია - ე.წ „ფერადი ექოსკოპია“ ნაყოფის სისხლძარღვებში სისხლის მიმოქცევის (მოძრაობისა და მიმართულების) გამოსაკვლევად. დოპლერომეტრიით დგინდება იქნეს იღებს თუ არა ნაყოფი საკმარისი რაოდენობით სისხლს, ჟანგბადსა და მკვებავ ნივთიერებებს დედის სისხლიდან);
• კარდიოტოკოგრაფია - (ნაყოფის გულისცემის სიხშირის დამოკიდებულება მოძრაობის აქტიურობაზე და საშვილოსნოს შეკუმშვებზე. მისი მთავარი ჩვენებაა ნაყოფის ჰიპოქსია).
ჩვეულებრივ, 29-ე კვირაში, სისხლის და შარდის საერთო ანალიზის გარდა სხვა გამოკვლევები იშვიათად ინიშნება, თუ ადგილი არ აქვს რაიმე სახის პრობლემას.
იშვიათად, შეიძლება საჭირო გახდეს ნაცხის ანალიზი ფლორაზე, აგრეთვე სისხლის ანალიზი შაქრის შემცველობაზე (ზედმეტი წონის შემთხვევაში).
ულტრაბგერითი გამოკვლევა ინიშნება მხოლოდ ექიმის გადაწყვეტილებით, თუ არსებობს რაიმე სახის ჩვენება.
ძალიან მალე ექიმთან ვიზიტის საჭიროება მოიმატებს, რადგან მშობიარობამდე სულ უფრო ცოტა დროა დარჩენილი. ეს არა მხოლოდ კარგია კონტროლის თვალსაზრისით, არამედ დამამშვიდებლად მოქმედებს ორსულზე და არ აძლევს მას აღელვების საშუალებას.
შესაძლო პრობლემები
 29-ე კვირაში შესაძლოა გაძლიერდეს ტკივილი ზურგის არეში. ორსულებს ხშირად აწუხებთ ყრუ და გაჭიანურებული ტკივილები წელის არეშიც.
29-ე კვირაში შესაძლოა გაძლიერდეს ტკივილი ზურგის არეში. ორსულებს ხშირად აწუხებთ ყრუ და გაჭიანურებული ტკივილები წელის არეშიც.
ამის მიზეზია ზურგის კუნთებზე და ხერხემალზე მზარდი დატვირთვა გაზრდილი და დამძიმებული მუცლის გამო.
ზოგჯერ ორსულმა შეიძლება იგრძნოს მტკივნეული დარტყმები მარჯვენა ნეკნების ქვემოთ ან ჭიპის არეში. ეს ნაყოფი ურტყამს მუცლიდან ქუსლებს ღვიძლის მიმართულებით, ან იდაყვს ჭიპის მიდამოში.
ზოგიერთ მომავალ დედას ამ პერიოდში აწუხებს ჰემოროი (ბუასილი). ამის მიზეზია გაზრდილი საშვილოსნოს დაწოლა მის ქვეშ მდებარე ვენებზე. შედეგად, სისხლი ვენებში ნელა მოძრაობს და აწვება სისხლძარღვების კედლებს. ამას კი მოსდევს ვენების დეფორმაცია და ჰემოროიდული კვანძების წარმოქმნა.
მიუხედავად იმისა, რომ ძირითად შემთხვევებში ჰემოროი ორსულობისა და მშობიარობის შემდეგ უკვალოდ ქრება, იგი მაინც განსაკუთრებულ ყურადღებას და კონტროლს საჭიროებს.
იხილეთ ვრცლად: ორსულობა და ჰემოროი
29-ე კვირაში ნორმიდან შესაძლო გადახრები:
• ნაადრევი მშობიარობის რისკი (იხილეთ ქვემოთ)
• ფეტო-პლაცენტალური უკმარისობა (ნაყოფის არასაკმარისი კვება ჟანგბადითა და მიკროელემენტებით);
• ჰესტოზი (გვიანი ტოქსიკოზი) - იხილეთ ვრცლად - ტოქსიკოზი
• ნაყოფის განვითარების შეჩერება - ნაყოფის განვითარების შეჩერებას უფრთხის ყველა დედა, რადაგან ამ ტერმინის ქვეშ წარმოუდგენიათ ნაყოფის საერთო განვითარების შეჩერება (თავის ტვინი, შინაგანი ორგანოები და სხვა...), თუმცა ამ შემთხვევაში იგულისხმება უბრალოდ ნაყოფის მასის მომატების შეჩერება.
ეს ნიშნავს, რომ დაბადების შემდეგ ბავშვი არ იქნება გონებრივად ჩამორჩენილი, უბრალოდ მისი წონა და ზომა იქნება ძალიან მცირე.
ამ პერიოდში შესაძლოა აქტიურად შემოგიტიოთ ისეთმა ნაცნობმა პრობლემებმა, როგორიცაა გულძმარვა და კუჭის შეკრულობა (ყაბზობა). ამის ძირითადი მიზეზი ჰორმონი პროგესტერონია, რომლის მოქმედებით სუსტდება კუჭ-ნაწლავის ტრაქტის კუნთები. მუცლის ღრუც გადავსებულია, ამიტომ ფერხდება საჭმლის მონელების პროცესი და შედეგად იღებთ - გაზების დაგროვებას, ყაბზობას და გულმძმარვას.
ამ ყველაფრის თავიდან ასაცილებლად რეკომენდებულია უჯრედისის შემცველი საკვების, საკმარისი რაოდენობის სითხის მიღება და მეტი მოძრაობა.
ქლამიდიოზი
სპეციალისტების შეფასებით, ქლამიდიოზით ყოველწლიურად ავადდება 2-დან 5 მილიონამდე ადამიანი. ქალების 20-დან 40%-ს, რომლებიც ეწევიან სექსუალურ ცხოვრებას, თუნდაც ერთხელ მაინც იყო დაინფიცირებული ამ დაავადებით.
სპეციალისტების შეფასებით, ქლამიდიოზით ყოველწლიურად ავადდება 2-დან 5 მილიონამდე ადამიანი. ქალების 20-დან 40%-ს, რომლებიც ეწევიან სექსუალურ ცხოვრებას, თუნდაც ერთხელ მაინც იყო დაინფიცირებული ამ დაავადებით.
ქლამიდიოზი ვენერიულ დაავადებებს მიეკუთვნება, მისი გამომწვევია ბაქტერია - ცჰლამყდია ტრაცჰომატის, რომელიც აზიანებს გარკვეული ტიპის უჯრედებს. ინფექცია გადადის სქესობრივი გზით, მათ შორის ორალური სექსით.
ყველაზე ხშირად ხდება ახალგაზრდა ადამიანების დაინფიცირება, რომელთაც ჰყავთ რამოდენიმე პარტნიორი. რისკის ჯგუფში შედიან ის ქალებიც, რომელთაც აქვთ ან ჰქონიათ სხვა სახის ვენერიული დაავადებები.
სამწუხაროდ, ორალური კონტრაცეპტივებით ქლამიდიოზისგან თავის დაცვა შეუძლებელია. ამ შემთხვევაში უფრო ეფექტურია კონტრაცეფციის ბარიერული მეთოდები, ისეთი, როგორიცაა დიაფრაგმები და პრეზერვატივები, სპერმიციდებთან ერთად.
ქლამიდიოზი ვერაგი დაავადებაა, ამის მიზეზი პირველ რიგში მისი რთული დიაგნოზირებაა, რადგან მიმდინარეობს უსიმპტომოდ.
თუ ქლამიდიოზის ინფექციის განკურნება არ მოხდა, შეიძლება სხვა სერიოზული დაავადებები გამოიწვიოს, მაგალითად - ადნექსიტი - საშვილოსნოს დანამატების (საკვერცხეებისა და საშვილოსნოს მილების) ანთება.
თუ დაავადებამ მიიღო ქრონიკული ან რეციდივული ხასიათი, შესაძლოა ქირურგიული ჩარევაც კი გახდეს საჭირო. ადნექსიტის შედეგი შეიძლება იყოს ისეთი არასასურველი და მწვავე პრობლემა, როგორიცაა - უნაყოფობა, აგრეთვე საშვილოსნოს გარე ორსულობის რისკი.
თუ მომავალი დედა დაინფიცირებულია ქალმიდიოზით, ნაყოფის დაინფიცირების რისკი 20-50%-ია. ახალშობილის დაინფიცირება ხდება დედისგან სამშობიარო გზების გავლის შემდეგ.
ინფექციამ შეილება დააზიანოს ნაყოფის თვალები (რისი განკურნებაც ადვილად ხდება), მაგრამ უფრო სერიოზულია ის, რომ მან შეიძლება პნევმონია გამოიწვიოს. ამ შემთხვევაში ბავშვის საავადმყოფოში გადაყვანა გახდება საჭირო.
როგორც უკვე ავღნიშნეთ, დაავადება უმეტეს შემთხვევებში მიმდინარეობს უსიმპტომოდ, თუმცა, ზოგჯერ აღინიშნება წვა გენიტალიის მიდამოებში, გამონადენი საშვილოსნოდან, მტკივნეული ან/და გახშირებული შარდვა, ტკივილი გავის ძვლის მიდამოში. აღსანიშნავია, რომ მსგავსი სიმპტომები აღენიშნებათ მამაკაცებსაც.
ქლამიდიოზის აღმოჩენა შესაძლებელია ბაქტერიოლოგიური გამოკვლევით (კულტურის გამოყოფა და დათესვა). თუმცა ეს ხანგრძლივი პროცესია. უკვე შემუშავებულია და პრაქტიკაში დანერგილია ექსპრეს-ანალიზი, რომელიც საშუალებას იძლევა ქლამიდიოზის არსებობა დაადასტუროს ანალიზის ჩაბარების დღესვე.
ქლამიდიოზი მგრძნობიარეა ტეტრაციკლინის ჯგუფის პრეპარატების მიმართ, ღუმცა ორსულობის დროს მათი გამოყენება არ შეიძლება. ამ შემთხვევაში ძირითადად ინიშნება ერიტრომიცინი.
ქალმიდიოზის ოდნავი ეჭვის შემთხვევაშიც, აუცილებლად უნდა აცნობოთ ექიმ-გინეკოლოგს ამ ფაქტის შესახებ. გაიკეთოთ საჭირო ანალიზები, ხოლო მისი აღმოჩენის შემთხვევაში, საჭიროა მკურნაკობის კურსი.
მკურნალობის კურსის დასრულების შემდეგ, ანალიზები ისე უნდა ჩაბარდეს და გადამოწმდეს ხართ თუ არა ჯანმრთელი.
ნაადრევი მშობიარობა
 ინფორმაციის უმეტესი ნაწილი ორსულობის 29-ე კვირისთვის ეხება ისეთ მოვლენას, როგორიცაა ნაადრევი მშობიარობა.
ინფორმაციის უმეტესი ნაწილი ორსულობის 29-ე კვირისთვის ეხება ისეთ მოვლენას, როგორიცაა ნაადრევი მშობიარობა.
ნაადრევი მშობიარობის ძირითადი სიმტომებია:
• სპაზმები და გაჭიანურებული ტკივილები მუცლის ქვემოთ, რომელიც ძალიან წააგავს მენსტრუაციის ტკივილებს;
• სიმძიმე მუცლის ქვემოთ, როცა გეჩვენებათ, რომ შარდის ბუშტსა და საშვილოსნოს რაღაც ძლიერ აწვება;
• გაძლიერებული ვაგინალური გამონადენი;
• შეტევისმაგვარი ტკივილები, რომელიც გრძელდება 30 წამზე მეტი (მხოლოდ ნუ შეგეშლებათ ცრუ სამშობიარო შეტევებში, როცა ადგილი ქვს საშვილოსნოს შესამჩნევ, მაგრამ არარეგულარულ შეკუმშვას);
• გამჭვირვალე, მოვარდისფრო, მოყავისფერო ან სისხლოვანი გამონადენი საშოდან;
• ვეღარ გრძნობთ ნაყოფის მოძრაობას;
ორსულობის ვადების მიხედვით, ნაადრევი მშობიარობა იყოფა სამ ჯგუფად:
1. ძალიან ადრეული - ნაადრევი მშობიარობა ხდება 22-27-ე კვირებში, როცა ნაყოფის მასა შედგენს 500-1000 გრამს;
2. ადრეული - ნაადრევი მშობიარობა ხდება 28-33-ე კვირებში, როცა ნაყოფის მასა შეადგენს 1000-2000 გრამს;
3. გვიანი - ნაადრევი მშობიარობა ხდება 34-37-ე კვირებში, როცა ნაყოფის მასა დაახლოებით 2500 გრამია;
თუ ამგვარი საფრთხე არსებობს და ექიმის დანიშნულებით გამოწერილი გაქვთ წოლითი რეჟიმი ან ნაადრევი მშობიარობის შესაჩერებელი პრეპარატები, აუცილებელია ამ დანიშნულების მკაცრად დაცვა, რადგან მასზე დიდწილადაა დამოკიდებული თქვენი და მომავალი პატარას ჯანმრთელობა.
თუ გაგიჩნდათ შეკითხვები ამა თუ იმ მედიკამენტის გამოყენების მიზანშეწონილობის შესახებ, ესაუბრეთ ამის შესახებ თქვენს ექიმს.
ნუ მოგერიდებათ დახმარებისთვის მიმართოთ სხვა სპეციალისტებსაც, მაგალითად პერინატოლოგს.
ნაადრევი მშობიარობის მიზეზები შეიძლება იყოს:
• საშვილოსნოს განვითარების მანკები (მაგალითად გაორებული საშვილოსნო, უნაგირისებრი და ორრქიანი საშვილოსნო);
• ძალიან დიდი საშვილოსნო მრავალნაყოფიანი ორსულობის დროს;
• ჭარბწყლიანობა;
• ტოქსიკოზი/პრეეკლამფსია;
• პლაცენტის აშრევება;
• პლაცენტის წინამდებარეობა;
• სანაყოფე გარსის ნაადრევი გარღვევა;
• საშვილოსნოს ყელის უკმარისობა;
• ნაყოფის განვითარების მანკები;
• ნაყოფის დაღუპვა;
• ჩატოვებული საშვილოსნოს შიდა სპირალი;
• გადატანილი (ორი და მეტი) აბორტი;
• დედის სერიოზული დაავადებები (მაგალითად ფარისებრი ჯირკვლის, თირკმლის დაავადებები, შაქრიანი დიაბეტი და სხვა);
• ორსულობა 16 წლამდე და 35 წლის შემდეგ;
• ჰესტაციური ასაკის (გესტაციური ასაკი) არასწორი განსაზღვრა;
• მძიმე შრომა,
• არასწორი ცხოვრების წესი (ალკოჰოლი, თამბაქო, ნარკოტიკები);
• და სხვა;
უცნობი მიზეზები - არის შემთხვევები, როცა ნაადრევი მშობიარობის მიზეზების დადგენა შეუძლებელია და იგი უცნობი რჩება.
ზოგიერთ ორსულს, ნაადრევი სამშობიარო მოქმედება ეწყება „ჩუმად“, ისეთი აღიარებული და შემაშფოთებელი სიმტომების გარეშე, როგორიცაა - წინასამშობიარო შეტევები, სისხლდენა, სანაყოფე გარსის დარღვევა, ტკივილი ზურგის გარეშე და გახშირებული შეტევებიც კი.
აქედან გამომდინარე, შეუძლებელია განისაზღვროს რა ზომების მიღებაა საჭირო, რომ მოხდეს ნაადრევი მშობიარობის შეჩერება.
იმისათვის, რომ ნაადრევი მშობიარობა თავიდან იქნას აცილებული, ძალიან მნიშვნელოვანია დადგენილი იქნას მისი ზუსტი მიზეზი, რათა მკურნალმა ექიმმა შეარჩიოს სწორი ტაქტიკა და განსაზღვროს:
»» სწორად არის თუ არა გამოთვლილი ორსულობის ვადები;
»» ნამდვილად აქვს თუ არა ადგილი ნაადრევ მშობიარობას;
»» გაგრძელდეს ორსულობა თუ საჭიროა ნაადრევი მშობიარობა;
ამიტომ, მცირე ეჭვის გაჩენის შემთხვევაშიც კი, რომ შესაძლოა ადგილი ჰქონდეს ნაადრევ მშობიარობას, საჭიროა დაუყონებლივ ექიმთან ვიზიტი და მისი საქმის ყურში ჩაყენება.
ექიმ-გინეკოლოგის ხშირი კონტროლის შემთხვევაში, პრობლემების რისკი მინიმუმამდე იქნება დაყვანილი.
გამონადენი - სანაყოფე წყლების დაღვრა შეიძლება მოხდეს ერთიანად, ან ნაწილ-ნაწილ, მცირე პორციებით.
ერთ და მეორე შეთხვევაშიც საჭიროა დაუყონებლივი რეაგირება და სამშობირო სახლში სასწრაფო ვიზიტი, რადგან ეს შეილება მშობიარობის დაწყებას მოასწავებდეს.
სანაყოფე წყლების გარჩევა სხვა სახის გამონადენისგან შესაძლებელია სპეციალური ტესტის საშუალებით, რომლის შეძენა შეიძლება აფთიაქებში.
ნორმაში, სანაყოფე წყლები წარმოადგენს უფერო, გამჭვირვალე, უსუნო სითხეს (ზოგჯერ მოტკბო სუნით).
თუ შეამჩნიეთ, რომ სითხის კონსისტენცია, ფერი ან სუნი შეიცვალა, საჭიროა ანალიზების ჩაბარება ინფექციების არსებობაზე.
თუ გამონადენი არის კოშტებით, ჩირქოვანი, ბუშტულებიანი ან ხაჭოსებრი, ეს შეიძლება ვენერიულ დაავადების არსებობას მოასწავებდეს.
ხოლო თუ გამონადენი სისხლოვანი, ალისფერი, ვარდისფერი ან ყავისფერია, ეს შესაძლოა პლაცენტის აშრევებაზე, ან ნაადრევ მშობიარობზე მეტყველებდეს.
თუ თეთერულზე შემთხვევით სისხლი აღმოაჩინეთ, მაშინვე ნუ იფიქრებთ, რომ ეს ნაადრევ მშობიარობის ნიშანია. ზოგჯერ, ჰემოროის შემთხვევაში ადგილი აქვს ხოლმე ანალური ხვრელიდან სისხლდენას, ამიტომ შესაძლოა სისხლის აღმოჩენის მიზეზი სწორედ ეს იყოს.
საშოდან გამინადენის გარდა, შესაძლოა 28-29-ე კვირის შემდეგ ადგილი ჰქონდეს მკერდიდან გამონადენს. ეს ხსენია და არ არის რეკომენდებული მისი გამოწურვა, უბრალოდ შეიმშრალეთ ხოლმე რბილი, არაუხეში ქსოვილით.
ცრუ სამშობიარო შეტევები - წინა კვირების მიმოხილვაში (შემდეგშიც) ავღნიშნეთ, რომ მე-3 ტრიმესტრში შესაძლოა ადგილი ჰქონდეს ცრუ სამშობიარო შეტევებს (მეცნიერულად - ბრეკსტონ-ჰიკსის შეტევები).
ცრუ სამშობიარო შეტევების სიმტომები განსხვავდება ნაადრევი მშობიარობის სიმტომებისგან სიხშირით, ძალით და ხანგრძლივობით.
ცრუ სამშობიარო შეტევები შეიძლება იგრძნობოდეს, როგორც საშვილოსნოს საერთო დაჭიმულობა - თითქოს საშვილოსნო იკუმშება ბურთივით, ან თითქოსდა ბავშვი გადაბრუნდა მუცლის შიგნით.
ჩვეულებრივ, ცრუ სამშობიარო შეტევები უმტკივნეულოა და თითქმის არასდროს გრძელდება ერთ საათზე მეტი.
მიუხედავად იმისა, რომ ცრუ სამშობიარო შეტევები აქვს ყველა ორსულს, მას შეიძლება ყველანი ვერ გრძნობდნენ, განსაკუთრებით პირველი ორსულობის დროს.
ამიტომ, არ ღირს ნერვიულობა ამგვარი შეტევების შემთხვევაში, რადგან ეს არ არის ნაადრევი მშობიარობის სიმტომი, უბრალოდ საშვილოსნო იზრდება, იწელება და „ვარჯიშდება“ ბავშვის დაბადების წინ, რაც ბუნებრივია და მიიჩნევა ნორმად.
ორსული ქალების დაახლოებით 10%-ს ემართება ნაადრევი მშობიარობისთვის დამახასიათებელი შეტევები, რომელიც სამშობიარო შეტევებისგან განსხვავებით ნამდვილ შეტევებს წარმოადგენს და ნიშნავს, რომ მშობიარობა დაიწყო ნაყოფის არასაკმარისად მომწიფებამდე.
ნაადრევი მშობიარობის სიმპტომები
 ნაადრევ მშობიარობად სპეციალისტები მიიჩნევენ მშობიარობას 28-დან 37 კვირამდე.
ნაადრევ მშობიარობად სპეციალისტები მიიჩნევენ მშობიარობას 28-დან 37 კვირამდე.
თუმცა, შეტევებს შესაძლოა ადგილი ჰქონდეს ნებისმიერ პერიოდში - 22-დან 37 კვირის ჩათვლით.
ასეთი შეტევები შეიძლება იყოს ხანმოკლე, შეიძლება გახშირდეს, გაგრძელდეს შეუჩერებლად, ჰქონდეს რეგულარული ხასიათი და გამოიწვიოს დიდი დისკომფორტი.
თუ ამ პერიოდის განმავლობაში თქვენ შეამჩნევთ უჩვეულო სიმტომებს, სასწრაფოდ საჭიროა ექიმ-გინეკოლგთან ვიზიტი, რომელიც მიიღებს გადაწყვეტილებას რისი გაკეთებაა საჭირო.
ნაადრევი მშობიარობის ძირითადი სიმტომებია:
• სპაზმები და გაჭიანურებული ტკივილები მუცლის ქვემოთ, რომელიც ძალიან წააგავს მენსტრუაციის ტკივილებს;
• სიმძიმე მუცლის ქვემოთ, როცა გეჩვენებათ, რომ შარდის ბუშტსა და საშვილოსნოს რაღაც ძლიერ აწვება;
• გაძლიერებული ვაგინალური გამონადენი;
• შეტევისმაგვარი ტკივილები, რომელიც გრძელდება 30 წამზე მეტი (მხოლოდ ნუ შეგეშლებათ ცრუ სამშობიარო შეტევებში, როცა ადგილი ქვს საშვილოსნოს შესამჩნევ, მაგრამ არარეგულარულ შეკუმშვას);
• გამჭვირვალე, მოვარდისფრო, მოყავისფერო ან სისხლოვანი გამონადენი საშოდან;
• ვეღარ გრძნობთ ნაყოფის მოძრაობას;
ექიმი შეაფასებს თქვენს მდგომარეობას და შესაძლოა შემოგთავაზოთ ჰოსპიტალიზაცია სამშობიარო სახლში.
პანიკა საჭიროა არ არის, რადგან ექიმებს უმეტეს შემთხვევაში შეუძლიათ შეაჩერონ სამშობიარო მოქმედება წოლითი რეჟიმის, პრეპარატების, ფსიქოთერაპიის, საშვილოსნოს ელექტრო რელაქსატორის, ნემსით რეფლექსო თერაპიის (აკუპუნქტურა) და ა.შ... საშუალებით.
ზოგადი რჩევები ნაადრევი მშობიარობის ასაცილებლად
აქ მოყვანილია ზოგადი, ელემენტალური რჩევები, რომელიც შეუძლიათ გამოიყენონ მომავალმა დედებმა ნაადრევი მშობიარობის თავიდან ასაცილებლად:
• თუ გაწუხებთ წყურვილის გრძნობა, დალიეთ ერთი ჭიქა წყალი ყოველ ორ საათში, რათა თავიდან აიცილოთ გაუწყლოვანება (ამან შეიძლება გამოიწვიოს საშვილოსნოს მგრძნობელობის ამაღლება).
თუ წყურვილის გრძნობა არ გაწუხებთ, ამ შემთხვევაში წყლის ნაძალადევი მიღება არ არის საჭირო. წყლის მიღების კონტროლი საჭიროა შეშუპების შემთხვევაშიც;
• სწორად იკვებეთ. მთელი ორსულობის განმავლობაში რეკომენდებულია 11.5-16 კგ-ის მომატება;
• მოერიდეთ ურთიერთობას ვირუსიან ავადმყოფებთან.
• ტუალეტში ყოფნის შემდეგ, ყოველთვის გაიწმინდეთ წინიდან უკანა მიმართულებით (და არა პირიქით), რათა არ მოხდეს ინფექციის შეტანა და გავრცელება;
• რასაც არ უნდა აკეთებდეთ, დაახლოებით საათში ერთხელ დაჯექით, დაისვენეთ და ფეხები ასწიეთ (ანუ შემოდევით რამეზე, მაგალითად პატარა სკამზე);
• არ ასწიოთ სიმძიმეეები და ზოგადად, მოერიდეთ ფიზიკურ სამუშაოს;
• თუ ასრულებთ რაიმე სახის ფიზიკურ სამუშაოს და ამ დროს დაგეწყოთ შეტევები, რასაც არ უნდა აკეთებდეთ, სასწრაფოდ შეჩერდით და დაისვენეთ;
• შეეცადეთ თავიდან აირიდოთ სტრესული სიტუაციები;
• ნაადრევი მშობიარობა - შიშის მომგვრელი პერსპექტივაა, თუმცა ბევრი ორსული გრძნობს მხოლოდ ცრუ სამშობიარო შეტევებს, რომელიც აბსოლიტურად უსაფრთხოა. ამიტომ ერიდეთ სტრესს და სტრესულ სიტუაციებს.
• იყავით მუდმივად ყურადღებით, თვალყური ადევნეთ საკუთარ შეგრძნებებს და რამე უჩვეულოს შემთხვევაში აუცილებლად მიმართეთ თქვენს ექიმ-გინეკოლოგს;
• რეგულარულად ჩაიტარეთ ყველა საჭირო და რეკომენდებული გამოკვლევა, მათ შორის ანალიზები ვირუსებზე, ინფექციებზე. აგრეთვე ულტრაბგერითი გამოკვლევა, კარდიოტოკოგრაფია და ასე შემდეგ.
თუ არსებობს ნაადრევი მშობიარობის საფრთხე და ექიმის დანიშნულებით გამოწერილი გაქვთ წოლითი რეჟიმი ან ნაადრევი მშობიარობის შესაჩერებელი პრეპარატები, აუცილებელია ამ დანიშნულების მკაცრად დაცვა, რადგან მასზე დიდწილადაა დამოკიდებული თქვენი და მომავალი პატარას ჯანმრთელობა.
ექიმი შეაფასებს თქვენს მდგომარეობას და შესაძლოა შემოგთავაზოთ ჰოსპიტალიზაცია სამშობიარო სახლში.
პანიკა საჭიროა არ არის, რადგან ექიმებს უმეტეს შემთხვევაში შეუძლიათ შეაჩერონ სამშობიარო მოქმედება წოლითი რეჟიმის, პრეპარატების, ფსიქოთერაპიის, საშვილოსნოს ელექტრო რელაქსატორის, ნემსით რეფლექსო თერაპიის (აკუპუნქტურა) და ა.შ...
თუ გაგიჩნდათ შეკითხვები ამა თუ იმ მედიკამენტის გამოყენების მიზანშეწონილობის შესახებ, ესაუბრეთ ამის შესახებ თქვენს ექიმს.
ნუ მოგერიდებათ დახმარებისთვის მიმართოთ სხვა სპეციალისტებსაც, მაგალითად პერინატალოგს.
სამწუხაროდ, ზოგიერთ შემთხვევაში ნაადრევი მშობიარობის თავიდან აცილება შეუძლებელია და ბავშვი ადრე მოევლინება ამ ქვეყანას.
ასეთი ბავშვი დღენაკლულ ახალშობილად მიიჩნევა, რომლის სრულყოფილ ბავშვად ჩამოყალიბებას განსაკუთრებული მოვლა და პირობები სჭირდება.
იხილეთ ვრცლად - ორსულობა და ნაადრევი მშობიარობა
დღენაკლული ბავშვი
 დღენაკლულად ითვლება ბავშვი, რომელიც დაიბადა 37-38 კვირაზე ადრე და მისი სხეულის მასა 2,5 კგ-ზე ნაკლებია.
დღენაკლულად ითვლება ბავშვი, რომელიც დაიბადა 37-38 კვირაზე ადრე და მისი სხეულის მასა 2,5 კგ-ზე ნაკლებია.
თუ ბავშვი დაიბადა ზუსტად 38 კვირაზე და მისი მასა 2,5 კგ-ია, ასეთი ბავშვი დღენაკლულად არ მიიჩნევა.
ჩვეულებრივ, ბავშვის წონა ძირითადად დამოკიდებულია ორსულობის ვადაზე, ხოლო დღენაკლული ბავშვი გარეგნული იერსახით მნიშვნელოვნად განსხვავდება ჩვეულებრივი, ვადაში დაბადებული ბავშვისგან.
თუმცა ეს არ ნიშნავს იმას, რომ დღენაკლული ბავშვი არ შეიძლება განვითარდეს და არ ჩამოყალიბდეს სრულყოფილ "პატარა ადამიანად" :-)
დღენაკლულ ბავშვებისთვის, მცირე მასისა და სიგრძის გარდა დამახასიათებელია:
• სხეულის არაპროპორციული აგებულება;
• კანის საფარი უფრო ჰიპერემირებულია (წითელია);
• ძვლები არის რბილი;
• ფრჩხილები ვერ ფარავს თითების ფალანგებს;
• თავის ქალას ნაკერები ღიაა არ არის შეზრდილი;
• გოგონებს განუვითარებელი აქვთ დიდი სასირცხვო ბაგეები (ისინი არ ფარავენ მცირე სასირცხვო ბაგეებს);
• ვაჟების სათესლე ჯირკვლები არ არის ჩამოსული სათესლე პარკში;
• და სხვა...
თუ ბავშვი დაიბადა 1.5 კგ-ზე დაბალი მასით, იგი ღრმა დღენაკლულ ბავშვად მიიჩნევა, ხოლო 1 კგ-ზე დაბალი მასის ბავშვი ითვლება ნაყოფად.
იმისათვის, რომ დადგენილი იქნას დღენაკლულობის სიმძიმის ხარისხი, ბავშვის წონისა და ორსულობის ვადის გარდა ითვალისწინებენ სხვა ნიშნებსაც, მაგალითად: პათოლოგიური მდგომარეობის არსებობა, სიმწიფის ხარისხის შესაბამისობა, დედის შესაძლო დაავადებები და ა.შ.
ამ დროს სიმწიფის ხარისხის სწორად განსაზღვრა, ძალიან მნიშვნელოვანი ფაქტორია.
ბავშვის სიმწიფის ხარისხი
სიმწიფის ხარისხი განისაზღვრება ბავშვის რეაქციით, რეფლექსების არსებობით, კუნთოვანი ტონუსის მდგომარეობით, მოძრაობის აქტიურობით, სითბოს შენარჩუნების უნარით და ა.შ.
შესაძლებელია დაახლოებით 2 კგ მასის დღენაკლული ბავშვები, თუ ისინი ჯანმრთელები არიან, იყვნენ აქტიურები, გააჩნდეთ კარგი ტონუსი, რეფლექსები, შეეძლოთ წოვა და ა.შ.
დაახლოებით 1.5 კგ მასის აღნიშნული რეაქციების მქონე ბავშვებსაც უკვე შეუძლიათ საწოვარადან საკვების მიღება სიცოცხლის პირველ კვირაში.
გაცილებით რთულია იმ ბავშვების მდგომარეობა, რომელთა დედების ორსულობის პერიოდი მიმდინარეობდა გართულებებით და შესაძლოა ნაყოფს აღენიშნებოდა მაგალითად საშვილოსნოსშიდა ჰიპოქსია. როგორც წესი, ასეთი ბავშვები იბადებიან უფრო მძიმე მდგომარეობით.
ყველაზე რთულად მიიჩნევიან ბავშვები რომელთა მასა დაბადებისას 900 გრ და უფრო ნაკლებია.
ერთი შეხედვით ამგვარი მძიმე მდგომარეობის მიუხედავად, ექიმებს გააჩნიათ ასეთი დაბალი წონის ბავშვების სიცოცხლისუნარიანობის შენარჩუნების დიდი გამოცდილება.
ბავშვის ბევრი შინაგანი ორგანოების მოუმწიფებლობის და პათოლოგიური რისკის არსებობის გამო ექიმები მაშინვე ატარებენ მთელი რიგი ღონისძიებების კომპლექსს, რათა შექმნან ყველაზე ოპტიმალური პირობები მისი სიცოცხლის დასაცავად.
დაბადებისთანავე, ბავშვის ზედა სასუნთქ გზებს ასუფთავებენ ლორწოსგან, შესაძლოა საჭირო გახდეს ლორწოს ამოსუფთავება კუჭიდანაც.
თუ ბავშვი არ სუნთქავს, ან დამოუკიდებად ცუდად სუნთქავს, მას უტარებენ ფილტვების ხელოვნურ ვენტილაციას. აგრეთვე მის ორგანიზმში შეჰყავთ ჯანმრთელობის შენარჩუნებისთვის აუცილებელი სამედიცინო პრეპარატები.
ბავშვს იმ მდგომარეობაზე დამოკიდებულებით, რომელშიც იმყოფება, ათავსებენ სპეციალურ ინკუბატორში, რომლის კონსტრუქციაც საშუალებას იძლევა დღენაკლულობის ხარისხის გათვალისწინებით შექმნილი იქნას აუცილებელი მიკროკლიმატი. აგრეთვე, აუცილებლად რეგულირდება ჰაერის ტენიანობა.
ინკუბატორი იძლევა ბავშვის სრულყოფილი მონიტორინგის და მთელი რიგი მანიპულაციების ჩატარების საშუალებას ისე, რომ საჭირო არ გახდეს ბავშვის იქედან ამოყვანა.
ბავშვის ინკუბატორში ყოფნის ხანგრძლივობა ასევე დამოკიდებულია მისი სხეულის მასაზე. შემდეგ ბავშვი გადაჰყავთ ღია ინკუბატორში, ხოლო გარკვეული პერიოდის შემდეგ სპეციალურ განყოფილებაში.
ზოგადი რჩევები დღენაკლული ბავშვების დედებს:
• თქვენი პატარა ჯერ-ჯერობით ოდნავ განსხვავებულია სხვა ბავშვებთან შედარებით, მაგრამ დროთა განმავლობაში და თქვენი დახმარებით იგი შეძლებს მალე დაეწიოს და გაუთანაბრდეს თანატოლებს ზრდა-განვითარებაში;
• იბრძოლეთ, რომ ასწავლოთ და მიაჩვიოთ მკერდით კვებას. ასეთი ბავშვებისთვის ეს ძალიან მნიშვნელოვანია;
• განსაკუთრებული ყურადღება მიაქციეთ კვებას. დღენაკლული ბავშვები ჭამენ ძალიან ნელა და ჩვეულებრივზე მცირე პორციებით, თუმცა რამდენადმე ხშირად, ვიდრე ჩვეულებრივი ბავშვები. საკვების მიღებას შორის ინტერვალი არ უნდა აღემატებოდეს 4 საათს.
• დღენაკლული ბავშვები ძალიან მგრძნობიარეები არიან ინფექციების მიმართ, ამიტომ აუცლებელია იმ შენობის იდეალური სისუფთავე, სადაც იმყოფება პატარა და რაც მთავარია, პირველ ხანებში მაქსიმალურად უნდა შეიღუდოს მისი მონახულების მსურველთა რაოდენობა.
• პირველ ხანებში, სპეციალისტების მიერ არ არის რეკომენდებული ბავშვის მუცელზე წოლა, ამიტომ უმჯობესია იგი ზურგზე დააწვინოთ;
• ბანაობის დროს, წყლის ტემპერატურა არ უნდა იყოს 37°С-ზე ნაკლები;
• შენობის ტემპერატურა, სადაც იმყოფება დღენაკლული ბავშვი, უნდა იყოს დაახლოებით 23-25°С;
• აუცილებელია საწოვარებისა და ბოთლების სტერლიზაცია. შეეცადეთ დაიცვათ ეს წესი, განსაკუთრებით ბავშვის სიცოცხლის პირველ თვეებში;
• დღენაკლული ბავშვებისთვის ძალიან სასარგებლოა სპეციალური მასაჟი, რომელიც უნდა ჩაატაროს გამოცდილმა სპეციალისტმა. მასაჟის მარტივი ელემენტები, მასაჟისტთან ვიზიტის შემდეგ, მშობლებს შეუძლიათ ჩაატარონ დამოუკიდებლადაც.
• დამატებითი საკვების მიცემა და ვაქცინაცია უნდა გაკეთდეს მკაცრად ექიმის რეკომენდაციით;
• აუცილებლად შეასრულეთ ექიმის ყველა რეკომენდაცია, ხოლო თუ მოხდება ისეთი სიტუაცია, რომ არ იცით როგორ მოიქცეთ, გამოიძახეთ სახლში ექიმი ან სასწრაფო დახმარება;
იხილეთ ვრცლად - ორსულობა და დღენაკლული ბავშვი
მომავალი ბავშვი
 მიუხედავად იმისა, რომ მშობიარობამდე დარჩენილია 10-11 კვირა, ნაყოფი მომწიფებულია და თითქმის მზად არის დასაბადებლად. მისი იმუნური სისტემა ფორმირებულია და თბორეგულცია მუშაობის პროცესშია.
მიუხედავად იმისა, რომ მშობიარობამდე დარჩენილია 10-11 კვირა, ნაყოფი მომწიფებულია და თითქმის მზად არის დასაბადებლად. მისი იმუნური სისტემა ფორმირებულია და თბორეგულცია მუშაობის პროცესშია.
ნაყოფის სხეული უკვე იძენს პროპორციებს, რომელიც დამახასიათებელია ახალდაბადებული ბავშვისთვის. ნაყოფის იერსახე სულ უფრო ჰგავს ახალდაბადებული ბავშვის იერსახეს. მისი კანი ნელ-ნელა სწორდება, ქრება პირველადი ღინღლი (ლანუგო).
ბლანტი დამცავი საპოხი, რომლითაც დაფარულია ნაყოფის კანი, მცირდება. სამაგიეროდ აქტიურად იზრდება კანქვეშა ცხიმის რაოდენობა (შეადგენს საერთო მასის დაახლოებით 4%-ს), შესაბამისად სხეულის ფორმებიც წინა პერიოდთან შედარებით უფრო დამრგვალებულია (ორსულობის ბოლოს ცხიმის რაოდენობა უკვე იმდენია, რომ ნაყოფი ხდება „პუტკუნა“, ნაკეცებიანი).
29-ე კვირისთვის ნაყოფი ყოველდღიურად ეჩვევა იმ მდგომარეობას, როცა უკვე შეძლებს დედის მუცლის გარეშე ცხოვრებას. ამ კვირაში დაბადების შემთხვევაში, მისი გადარჩენის შანსი 90%-ია.
ამ პერიოდში სრულყოფილად მუშაობს საშარდე სისტემა: ნაყოფის თირკმლებს შეუძლია ყოველდღიურად გამოიმუშავოს დაახლოებით ნახევარი ლიტრი სითხე და გამოიტანოს შარდი სანაყოფე წყლებში.
სტაბილურობას იძენს ნაყოფის სისხლის შემადგენლობა, ფორმირებულია ნაყოფის ძვლის ტვინიც, რომელიც უკვე ასრულებს სისხლწარმოქმნის ფუნქციას.
საბოლოოდ არის ფორმირებული საჭმლის მომნელებელი სისტემა, რომელიც მზად არის გადაამუშავოს პირველი საკვები.
შესაძლოა შეუძლებლად მოგეჩვენოთ, მაგრამ პატარას უკვე შეუძლია მზერის ფოკუსირება, ესმის ხმები, უფრო ფაქიზად არჩევს ბგერებს (უფრო დაბალს, ვიდრე მაღალს) აღიქვამს შუქს და განვითარებული აქვს ყნოსვა.
კბილებზე უკვე ჩნდება ემალი, თუმცა იგი ჯერ-ჯერობით ღრძილების ქვეშ არის დამალული.
გრძელდება თავის ტვინის განვითარებაც, რომლის ხვეულები და ნაოჭები უფრო მკაფიოდაა გამოკვეთილი.
სასქესო ორგანოები ჯერ კიდევ ფორმირების პროცესშია, თუმცა საკმაოდ კარგადაა გამოხატული.
მოქმედებას იწყებს ბავშვის საკუთარი იმუნური სისტემა, თუმცა ანტისხეულებს იგი ჯერჯერობით დედის სისხლიდან იღებს.
ინტენსიურად გრძელდება კუნთოვანი ქსოვილების ფორმირება, ამასთან ბავშვი უკვე გრძნობს სივიწროვეს, ამიტომ იგი უკვე არათუ მოძრაობს მუცელში, არამედ მუხლებითა და იდაყვებით ურტყამს საშვილოსნოს კედლებს, ამ დარტყმებს დედა უფრო თვალსაჩინოდ და ზოგჯერ მტკივნეულადაც კი გრძნობს.
ამ დროს ძალიან მარტივია მომავალმა დედამ გაიგოს სად არის ნაყოფის თავი - ეს ბავშვის ყველაზე უძრავი ნაწილია.
ორსულობის 29-ე კვირისთვის, ნაყოფის ზრდა ჩქარდება. მისი ზომა დაახლებით 38,5-40 სმ, წონა კი 1350-1500 გრ-ია.
| ორსულობის კალენდარი |
| ყველაფერი ორსულობის შესახებ |
| ყველაფერი მომავალი დედებისთვის ონლაინ მაღაზიაში MyWish.ge |
 |













